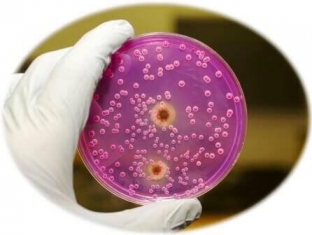

Thrush is popularly called the defeat of certain parts of the body by fungi of the genus Candida. The types of this disease are classified depending on localization (oral cavity, genitourinary system, skin and nails, internal organs), course characteristics (carriage, acute or chronic thrush), persistence (persistent or recurrent form), prevalence (superficial, systemic form, candida sepsis), by the nature of the growth of the Candida fungus (invasive and non-invasive form) and by clinical forms (pseudomembranous, atrophic, granulomatous candidiasis). Today estet-portal.com will talk about the treatment of chronic thrush in women.
Chronic thrush – causes and symptoms of the development of the disease
Chronic thrush most often develops as a result of improper treatment of the acute form of the disease, weakening of the body's defenses or re-infection.
Contribute to the development of the chronic form of candidiasis and concomitant infectious diseases, and hormonal imbalance, and bowel disease, and long-term use of antibiotics.
In order to prevent the transition of acute thrush into a chronic form, the doctor may prescribe the following drugs:
- Diflucan (read more about the drug on website);
- Pimafucin;
- Canison;
- Terzhinan.
Symptomatic characteristic of chronic thrush:
- symptoms persist for more than two months;
- disease progresses;
- symptoms often become less pronounced;
- no vaginal discharge;
- the only symptom may be itching in intimate areas;
- there may be manifestations of thrush in other localizations (in the mouth, on adjacent areas of the skin, etc.).
To prevent the development of a chronic form of candidiasis, it is necessary to consult a doctor in time and undergo treatment if symptoms of an acute form of thrush appear, namely:
- abundant vaginal discharge (with a characteristic sour odor and often curdled consistency, color – white);
- itching in the area of intimate places;
- redness and swelling of the labia and vaginal walls;
- sexual intercourse and urination are accompanied by pain and/or discomfort.
Peculiarities of treatment of chronic thrush in women
It is important to understand that from chronic & nbsp; thrush is much more difficult to get rid of than the acute form of this disease. Therefore, treatment is carried out exclusively under the supervision of a physician. To prescribe an appropriate treatment regimen, it will be necessary to undergo a comprehensive examination, which will enable the doctor to determine the true cause of the transition from acute thrush to the chronic form.
If comorbidities are detected, it is necessary to take up appropriate treatment, which is also prescribed by the attending physician. The drug regimen is also prescribed by a specialist, based on a specific case.
Self-treatment of chronic thrush is excluded.
Treatment of the chronic form of candidiasis is much more difficult than in the acute form of the disease, since it involves not only the fight against a fungal infection, but also the correction of concomitant factors that act as triggers for the disease. The patient should prepare to take antifungal drugs for several months, along with the use of vaginal suppositories and other medicines prescribed by the doctor.
In addition, for the successful treatment of chronic thrush, it is necessary that the sexual partner also undergo appropriate examinations and take the drugs prescribed for prevention or treatment, which are also selected by the doctor, based on the characteristics of the particular case.
Estet-portal.com reminds: in order to prevent possible complications of this disease (damage to the bladder, kidneys, adhesions and inflammation, disorders in the gastrointestinal tract and even infertility), you must consult a doctor in a timely manner and follow his recommendations, follow the dosage and the regularity of taking the drugs!
Add a comment